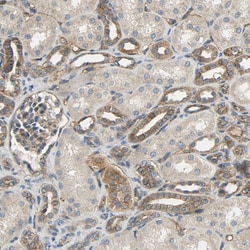
Invitrogen KIAA1217 Polyclonal Antibody 100 &mu;L; Unconjugated:Antibodies

missing translation for 'onlineSavingsMsg'
Learn More
Learn More
Invitrogen™ KIAA1217 Polyclonal Antibody


Rabbit Polyclonal Antibody
Marca: Invitrogen™ PA552137
Questo articolo non è restituibile.
Consulta la politica di reso
Descrizione
Immunogen sequence: KEEPHKLDSL LKRVRSMTDV LTMLRRHVTD GLLKGTDAAQ AAQYMAMEKA TAAEVLKSQE EAAHTSGQPF HSTGAPGDAK SEVVPLSGMM VRHAQSSPVV IQPSQ Highest antigen sequence identity to the following orthologs: Mouse - 86%, Rat - 86%.
KIAA1217 required for normal development of intervertebral disks.
Specifica
| KIAA1217 | |
| Polyclonal | |
| Unconjugated | |
| KIAA1217 | |
| KIAA1217; likely orthologue of Mus musculus enhancer trap locus 4; RP11-324E23.1; sickle tail protein homolog; SKT | |
| Rabbit | |
| Antigen affinity chromatography | |
| RUO | |
| 56243 | |
| Store at 4°C short term. For long term storage, store at -20°C, avoiding freeze/thaw cycles. | |
| Liquid |
| Immunohistochemistry (Paraffin), Immunocytochemistry | |
| 0.10 mg/mL | |
| PBS with 40% glycerol and 0.02% sodium azide; pH 7.2 | |
| Q5T5P2 | |
| KIAA1217 | |
| Recombinant protein corresponding to Human KIAA1217. Recombinant protein control fragment (Product #RP-88756). | |
| 100 μL | |
| Primary | |
| Human | |
| Antibody | |
| IgG |
Correzione del contenuto del prodotto
Fornite il vostro feedback sul contenuto del prodotto compilando il modulo sottostante.
Titolo del prodotto
Individuate un'opportunità di miglioramento?Condividi una correzione di contenuto